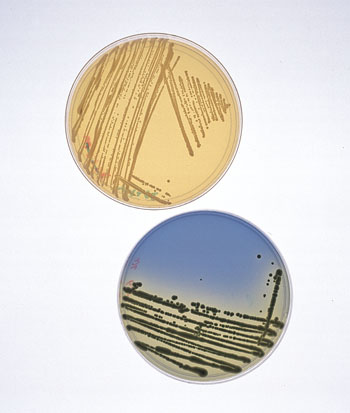
Yeast in petri dishes.

How Yeast is Made
Home winemaking continues to gain in popularity. The quality of wines kits has greatly improved over the past several years and, as a consequence, the first experience of many folks curious about winemaking has been positive. These positive first experiences often lead to enthusiastic new participants in our hobby. For intermediate and advanced winemakers, the wave of newcomers trying their hand at winemaking has led to better-stocked home winemaking shops and a greater amount of products available to home winemakers.
In particular, the number of yeast strains available has increased in recent years. Our Yeast Strains Chart presents our compilation of all the wine yeast strains that are now at your fingertips. Just a few short years ago, this list would have been shorter.
If you’ve ever wondered how yeast is made, I’ll give a quick overview of the process. First off, let’s get our terminology straight and recognize that yeast is not “made,” in the sense of it being manufactured from component parts. Yeast is a living organism and companies that sell yeast strains for winemaking are “merely” selecting, storing, growing and packaging their yeast strains for sale. However, since it’s easier to say “made” than “selected, stored, grown and packaged” over and over, I’ll use “made” in this article.

The yeast strains for sale today originated in the wild. In the very earliest days of winemaking, all wine fermentations were spontaneous. The array of yeast and bacteria living on the yeast skins — and floating in the air or residing in the winemakers fermenter — would begin consuming the juice. Because some organisms were better able to handle the diet of simple sugars, low pH and rising alcohol levels in fermenting wine, these organisms eventually came to dominate the fermentation. One species of unicellular fungus, now called Saccharomyces cerevisiae, would most often “win” the competition in these ancient fermentations (just as it will today if you spontaneously ferment your juice).
Since wild S. cerevisiae lived on rotting fruit, it was used to quickly exploiting sudden appearances of large amounts of simple sugars. It was also used to the acidic environment found in most fruits and since it grew quickly when resources (fallen fruit) became available, is was used to living in high-alcohol environments and was able to tolerate its presence better than most other microorganisms. (Many other microorganisms ferment sugars to produce alcohol. However, most grow at such a slow rate that the alcohol never builds up in their environment to the levels it typically does in rotting fruit.)
As time went on, winemakers began to save strains of yeast that performed better than average and some cultures were used over and over. Through many rounds of fermentation and selection, the characteristics of the yeast were shaped to suit the wishes of the winemaker. With the advent of modern biology and the tools to isolate and study individual yeast strains, winemakers could sanitize their juice and then pitch pure strains of yeast to ferment it. This would yield more consistent fermentations and, in most cases, yield better wine. The yeast you pitch today is just the tame descendent of a wild yeast that only wanted to stake its claim to a rotting grape and bud off a few daughter cells.
Raising and Packing Yeast
The more recent history of the yeast you use goes something like the following. (Note that procedures vary among companies and much of what they do is proprietary, so the following is a generalized explanation, for which some key details are not available.)
At the companies that make yeast, yeast strains are stored at 4 °C (39 °F) on agar slants or at -80 °C (-112 °F) in glycerol. Cells can be stored on slants, which are test tubes with some agar “jello” in them that the yeast live on, for weeks. Cells frozen in glycerol can be kept for months before they are used. Before a strain is taken out of storage to be grown up, the company will run tests on the strain to make sure it is correctly identified and the yeast is performing as it should. The yeast is then transferred to a liquid media, often made from molasses, with added nutrients to supply nitrogen, phosphorous, vitamins and minerals. The culture is stepped up several times to increase the number of cells.
Once a sizable culture has been grown, the culture enters a rapid cell production phase in which the yeast are fed continuously. This process occurs in very large fermenters under conditions that let the yeast multiply rapidly and reach very high densities — much higher than they would reach in a normal wine fermentation. In other words, Champagne yeast isn’t grown in huge batch of white wine. For one thing, the concentration of sugars is kept low compared to wine must as yeast are less stressed in low-sugar environments. In addition, the yeast culture is constantly aerated, which stimulates yeast growth. A constant supply of sugars, nutrients and oxygen keep the yeast growing at a high rate — not the maximum possible, but the fastest rate that still yields yeast that will perform well in a wine fermentation.
Next, the rate of cell division is slowed and, in preparation for drying, nutrients are added to the yeast to help it survive the process. Other, unspecified agents, may also be added to help stabilize the yeast. The cells are then harvested, separated from their media and dried to a cream with between 15 and 20% solids. The cream is pressed into a cake and extruded through a mold to produce yeast “noodles.” The noodles are then dried.
There are many ways to dry yeast cells, but a popular method these days is to use an air lift drier. In an air lift, the yeast sit on a grate and hot air is forced up through the yeast “noodles.” The yeast are churned sort of like corn kernels in a hot air popper. (An older way of drying the yeast is to put the yeast in trays and have it ride on a conveyer belt through a long oven.) The yeast are slowly dried until they contain 94% solids. The dried yeast is then vacuum packed into sachets, which have a shelf life of two years when stored under 10 °C (50 °F). The viability of the dried yeast is 86%, but each dried yeast packet contains about 10 billion living cells per gram. Thus an 11 g pouch would contain about 110 billion cells.
Cultured yeast contains trace amounts of bacteria and wild yeast. This level is far below the point that it would influence a wine fermentation (and certainly incredibly far below the level that would occur with a spontaneous fermentation). The practical experience of winemakers also shows that this level of contamination does not result in flawed wine.
“Undrying” Yeast
In order to perform at its best, dried yeast should be rehydrated. The instructions for doing this are simple. Take a clean, sanitized measuring cup and add about 2–4 fl. oz. (50–100 mL) of water at 95–112 °F (35–44 °C). For exact water volume and temperature, consult the back of your yeast sachet; each strain is different, so don’t use a generic procedure. Sprinkle the yeast into the water and whisk it in lightly with a clean, sanitized fork or whisk. All you need to do is get all the yeast wet, not work it into a froth. (It will do that on its own). Let the mixture sit for 15 minutes, then pitch it to your wort. This procedure is simple, but it’s important to follow the instructions carefully and not “improve” upon them. There’s a reason for every aspect of the procedure.
Warm water — as opposed to juice or a sugar solution — is the rehydration media because, for optimal health, the yeast need to rehydrate quickly. You want the shriveled cell wall to “pop” open and spring into its natural shape, not slowly unfold. The presence of sugars or other substances in the rehydration water slows the flow of water into the cells. Likewise, until the yeast cells rehydrate and “get their bearings,” they are unable to regulate what passes through their cell membrane very well. Juice contains substances (for example sugars) that are beneficial to yeast, but also substances that are toxic to yeast. Healthy yeast cells don’t take these substances in. However, yeast cells being rehydrated may let some in while they’re still “stunned” from being rehydrated. Once the 15 minutes have passed, the yeast are “inflated,” physiologically active and sitting in water. At this point, continuing to sit in water is not doing them any good. This is why you need to pitch the yeast immediately after rehydration.
New Sources
For years, most home winemakers have used dried yeasts and companies such as Lallemand and Red Star have supplied most of it. But recently, two new kids have shown up on the block — White Labs and Wyeast. These companies, that started out supplying yeast to home beermakers now offer yeast to home winemakers, with one difference — their yeast is packaged in a liquid culture.
White Labs packages their yeast in plastic tubes. The tubes are actually the blanks for larger plastic bottles, which is why the walls of the tubes are so thick. The 35 mL yeast vials contain from 70–130 billion cells. Wyeast’s 125 mL Activator packs are advertised to contain 100 billion cells, but actually average around 120–130 billion cells. Wyeast strains come in a pouch with an interior pouch of nutrients. When “smacked,” the inside pouch ruptures, feeds to yeast in the outer pack and causes the whole package to swell. (The idea for smack packs, incidentally, came from David Logsdon, president of Wyeast who wanted a way for brewers to “feed” the yeast, without the possibility of contaminating the culture.) In reality, with fresh yeast, you don’t have to wait for the package to swell, but quick swelling is a sure sign the pack contains fresh, healthy yeast.
At packaging, the yeast cells in both White Labs and Wyeast packages are 99% viable. Both companies date their packages so winemakers can assess their freshness.
Your local winemaking shop should have its liquid yeast refrigerated and, if you order from a website, you should opt for cooling packs (if available) to keep the yeast cold during shipment. At home, store your liquid yeast in your refrigerator. If a liquid yeast package freezes, the yeast cells inside will rupture and die. Dried yeast should be refrigerated, but is much more tolerant of being stored at room temperature. Before pitching liquid yeast to your juice, you should take it out and let it warm to room temperature.
Liquid yeast producers make their yeast in a way that is very similar to dried yeast manufacturers. The big difference, of course, is that liquid yeast remains in a liquid media, as opposed to being dried. One interesting difference in how liquid yeast is made has to do with the frequency and scale it at which it is produced. Because liquid yeast needs to be fresh to be useful in winemaking, it is grown in much smaller quantities than dried yeast, which can be stored for much longer times (up to two years). “The cost per cell for liquid yeast is much higher than with dried yeast,” says Chris White. While dried yeast sachets cost $1.50–2.00, liquid yeast strains cost about 6 dollars.
Choosing Your Yeast
The chart on page 31 should get you started in selecting the proper yeast strains for your fermentations. At first, you will probably want to follow the advice that has built up over years of experience — after all, there’s a reason Champagne yeast is called Champagne yeast. At some point, however, you may wish to forge out on your own and try to find the perfect mix of yeast strain, varietal, terroir and winemaking practices.